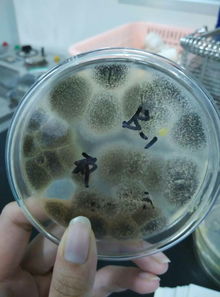
什么是霉菌?

霉菌是什么?
霉菌是真菌的一种,其特点是菌丝体较发达,无较大的子实体。
同其他真菌一样,也有细胞壁,寄生或腐生方式生存。
霉菌有的使食品转变为有毒物质,有的可能在食品中产生毒素,即霉菌毒素。
自从发现黄曲霉毒素以来,霉菌与霉菌。
什么是霉菌?
霉菌是丝状真菌的俗称,意即“发霉的真菌”,它们往往能形成分枝繁茂的菌丝体,但又不像蘑菇那样产生大型的子实体。
构成霉菌体的基本单位称为菌丝,呈长管状,宽度2—10微米,可不断自前端生长并分枝。
在固体上生长时,部分。
霉菌是什么?
霉菌是什么?霉菌是真菌的一种,其特点是菌丝体较发达,无较大的子实体。
同其他真菌一样,也有细胞壁,寄生或腐生方式生存。
霉菌有的使食品转变为有毒物质,有的可能在食品中产生毒素,即霉菌毒素。
自从发现黄曲霉毒素以来,霉菌与霉菌。
霉菌是什么生物
霉菌是丝状真菌的俗称,意即“发霉的真菌”,它们往往能形成分枝繁茂的菌丝体,但又不象蘑菇那样产生大型的子实体。
在潮湿温暖的地方,很多物品上长出一些。
肉眼可见的绒毛状、絮状或蛛网状的菌落,那就是霉菌。
其细胞壁主要。
霉菌是什么?
霉菌是形成分枝菌丝的真菌的统称,是真菌的一部分,其特点是菌丝体较发达,无较大的子实体。
同其他真菌一样,也有细胞壁,寄生或腐生方式生存。
在固体基质上生长时,部分菌丝深入基质吸收养料,称为基质菌丝或营养菌丝;向。